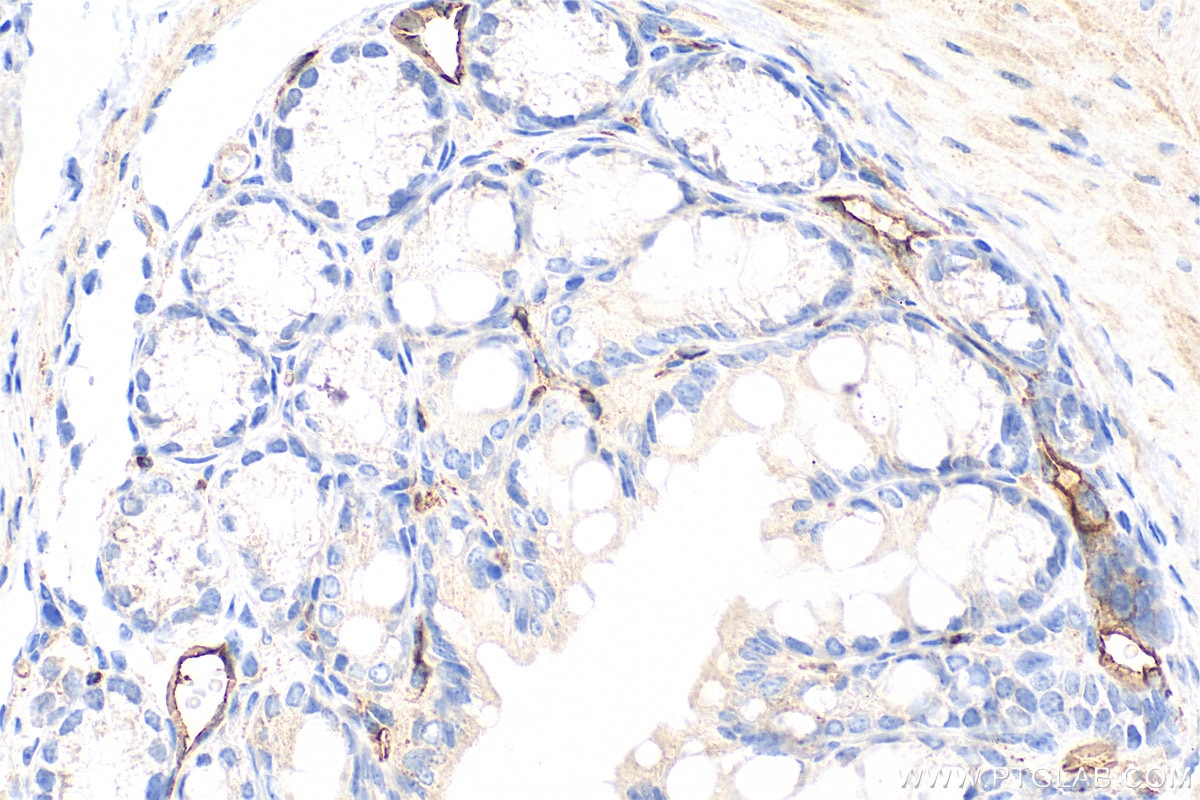
Immunohistochemistry (IHC) staining of mouse colon tissue using PLVAP Polyclonal antibody (14452-1-AP)

Tested Applications
| Positive WB detected in | HEK-293 cells, L02 cells, mouse liver tissue, rat liver tissue |
| Positive IHC detected in | mouse colon tissue Note: suggested antigen retrieval with TE buffer pH 9.0; (*) Alternatively, antigen retrieval may be performed with citrate buffer pH 6.0 |
Recommended dilution
| Application | Dilution |
|---|---|
| Western Blot (WB) | WB : 1:1000-1:9000 |
| Immunohistochemistry (IHC) | IHC : 1:1000-1:4000 |
| It is recommended that this reagent should be titrated in each testing system to obtain optimal results. | |
| Sample-dependent, Check data in validation data gallery. | |
Published Applications
| WB | See 7 publications below |
| IF | See 1 publications below |
Product Information
14452-1-AP targets PLVAP in WB, IHC, IF, ELISA applications and shows reactivity with human, mouse, rat samples.
| Tested Reactivity | human, mouse, rat |
| Cited Reactivity | human, mouse, pig |
| Host / Isotype | Rabbit / IgG |
| Class | Polyclonal |
| Type | Antibody |
| Immunogen |
CatNo: Ag5963 Product name: Recombinant human PLVAP protein Source: e coli.-derived, PGEX-4T Tag: GST Domain: 63-442 aa of BC056414 Sequence: TERRAEGLYSQLLGLTASQSNLTKELNFTTRAKDAIMQMWLNARRDLDRINASFRQCQGDRVIYTNNQRYMAAIILSEKQCRDQFKDMNKSCDALLFMLNQKVKTLEVEIAKEKTICTKDKESVLLNKRVAEEQLVECVKTRELQHQERQLAKEQLQKVQALCLPLDKDKFEMDLRNLWRDSIIPRSLDNLGYNLYHPLGSELASIRRACDHMPSLMSSKVEELARSLRADIERVARENSDLQRQKLEAQQGLRASQEAKQKVEKEAQAREAKLQAECSRQTQLALEEKAVLRKERDNLAKELEEKKREAEQLRMELAIRNSALDTCIKTKSQPMMPVSRPMGPVPNPQPIDPASLEEFKRKILESQRPPAGIPVAPSSG Predict reactive species |
| Full Name | plasmalemma vesicle associated protein |
| Calculated Molecular Weight | 51 kDa |
| Observed Molecular Weight | 50-60 kDa |
| GenBank Accession Number | BC056414 |
| Gene Symbol | PLVAP |
| Gene ID (NCBI) | 83483 |
| RRID | AB_2166100 |
| Conjugate | Unconjugated |
| Form | Liquid |
| Purification Method | Antigen affinity purification |
| UNIPROT ID | Q9BX97 |
| Storage Buffer | PBS with 0.02% sodium azide and 50% glycerol, pH 7.3. |
| Storage Conditions | Store at -20°C. Stable for one year after shipment. Aliquoting is unnecessary for -20oC storage. 20ul sizes contain 0.1% BSA. |
Background Information
Plasmalemma vesicle-associated protein (PLVAP) is an endothelial-associated protein that is involved in endothelial diaphragm formation and maintenance of basal vascular permeability. At the same time, PLVAP has roles in immunity by facilitating leukocyte diapedesis at inflammatory sites and controlling peripheral lymph node morphogenesis and the entry into soluble ags into lymph node conduits .(PMID: 36884119, PMID: 37810232)
Protocols
| Product Specific Protocols | |
|---|---|
| WB protocol for PLVAP antibody 14452-1-AP | Download protocol |
| Standard Protocols | |
|---|---|
| Click here to view our Standard Protocols |
Publications
| Species | Application | Title |
|---|---|---|
Neuron The Wnt Inhibitor Apcdd1 Coordinates Vascular Remodeling and Barrier Maturation of Retinal Blood Vessels. | ||
J Virol Porcine Epidemic Diarrhea Virus Infection Disrupts the Nasal Endothelial Barrier To Favor Viral Dissemination. | ||
Front Pharmacol Stimulatory G-Protein α Subunit Modulates Endothelial Cell Permeability Through Regulation of Plasmalemma Vesicle-Associated Protein. | ||
Biochem Biophys Res Commun Retinal VEGFA maintains the ultrastructure and function of choriocapillaris by preserving the endothelial PLVAP. | ||
bioRxiv Glutamatergic neuronal activity regulates angiogenesis and blood-retinal barrier maturation via Norrin/β-catenin signaling | ||
Mol Neurobiol Canonical Wnt Pathway Maintains Blood-Brain Barrier Integrity upon Ischemic Stroke and Its Activation Ameliorates Tissue Plasminogen Activator Therapy. |
Reviews
The reviews below have been submitted by verified Proteintech customers who received an incentive for providing their feedback.
FH Michelle (Verified Customer) (12-01-2023) | This antibody works very well for PLVAP westernblot analysis. We detected strong und specific PLVAP bands, even with this relatively high dilution of 1:4500.
|